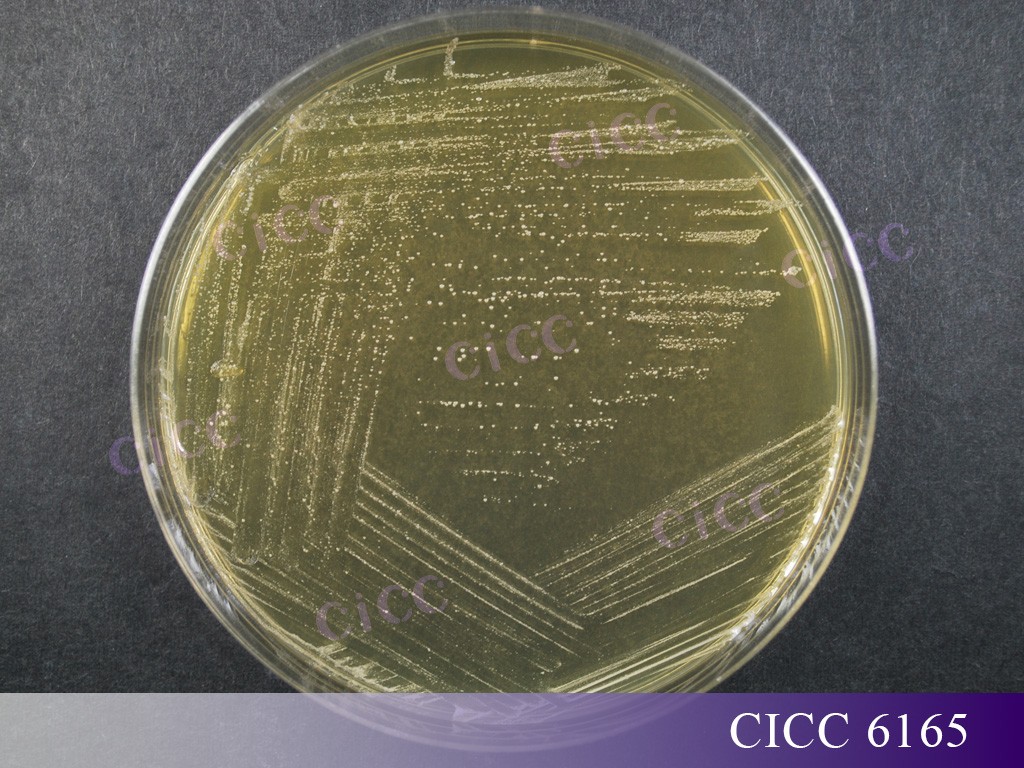

動物雙歧桿菌
動物雙歧桿菌 Bifidobacterium animalis
放線菌門 Actinomycetota
放線菌綱 Actinomycetes
雙歧桿菌目 Bifidobacteriales
雙歧桿菌科 Bifidobacteriaceae
雙歧桿菌屬 Bifidobacterium
動物雙歧桿菌是廣泛應用于食品和保健品行業的益生菌之一。本文將詳細介紹動物雙歧桿菌的分類學變遷、研究進展、應用情況、特征特性和國內外保藏情況。
發展歷史
1899年:巴斯德研究院的Tissier首次在以母乳喂養的嬰兒糞便中發現并分離出來雙歧桿菌,Tissier將這種分離到的革蘭氏陽性、變彎的或分叉的桿菌命名為普通分叉桿菌(Bacillus bifiduscommunis)或分叉桿菌(Bacillus bfidus)[1]。
1969年:Mitsuoka[2]從豬、雞、大鼠和豚鼠等各種動物的糞便中分離出三株雙歧桿菌,其中一株命名為長雙歧桿菌動物亞種(Bifidobacterium longurn subsp. animalis)。
1971年:Scardovi、Zani和Trovatelli[3]等人通過對雙歧桿菌屬物種間DNA-DNA同源性研究發現,B. longurn subsp. animalis與長雙歧桿菌無同源性關系。
1974年:Scardovi和Trovatelli[4]等人進一步研究,將來自雞、大鼠和兔子糞便以及污水的22株雙歧桿菌菌株形成了一個單一的脫氧核糖核酸(DNA) 同源組,與B. longum subsp. animalis完全同源。這組菌株與雙歧桿菌屬已知物種的DNA相關性范圍為5%至40%,建議將B. longum subsp. animalis命名為動物雙歧桿菌(Bifidobacterium animalis)。
1997年:Meile[5]等研究顯示乳雙歧桿菌(Bifidobacterium lactis)與動物雙歧桿菌(Bifidobacterium animalis)的密切相關性,曾將其描述為動物雙歧桿菌[4]。基于形態學特征、16S rDNA序列分析和DNA-DNA雜交,Cai[6]等人提議乳雙歧桿菌與動物雙歧桿菌應該是同物異名。但是,Ventura和Zink[7]依據脈沖場凝膠電泳(PFGE)研究了所有動物雙歧桿菌和乳雙歧桿菌的個體性,使用ERIC-PCR技術在雙歧桿菌物種水平上進行了清晰的鑒定;Zhu[8]等人對HSP60基因進行擴增,都認為乳雙歧桿菌和動物雙歧桿菌應該在亞種水平被劃分為兩個分類單元。
2004年:Masco[9]等人確認了這一分類地位,將動物雙歧桿菌重新細分為動物雙歧桿菌動物亞種(Bifidobacterium animalis?subsp.?animalis)和動物雙歧桿菌乳亞種(Bifidobacterium animalis?subsp.?lactis)。這兩個亞種也可以通過BOX-PCR,熒光擴增片段長度多態性(FAFLP)DNA指紋圖譜,atpD和groEL基因序列分型以及PAGE電泳來區分[9, 10]。
2020年:我國《可用于食品的菌種名單》和《可用于嬰幼兒食品的菌種名單》將動物雙歧桿菌(B. animalis)更名為動物雙歧桿菌動物亞種(B. animalis?subsp.?animalis),乳雙歧桿菌(B. lactis)更名為動物雙歧桿菌乳亞種(B. animalis?subsp.?lactis)[11]。
研究進展
動物雙歧桿菌是天然存在于結腸中的優勢菌群之一,是最早定殖于人體腸道的一類微生物,有利于腸道免疫的形成[12],在調節腸道菌群平衡與促進腸道正常發育、增強機體免疫力、提高抗病能力等方面具有重要作用,特別是嬰兒期的早期定殖,有利于腸道免疫的形成[13]。
維持腸道菌群平衡
研究表明,雙歧桿菌大多數物種對強酸條件的抵抗力較差,但動物雙歧桿菌表現出較高的胃酸和膽汁耐受性[13, 14],在腸道內具有粘附力[15]。Martins[16]等研究表明,灌胃B. animalis subsp . lactis能顯著降低鼠傷寒沙門氏菌感染無菌小鼠糞便中致病菌的數量,起到與病原菌拮抗的作用,同時顯著提高模型小鼠腸道中sIgA和IL-10的含量。
增強機體免疫力
在Gill[17]等人的研究中,健康老年受試者通過膳食補充益生菌乳雙歧桿菌HN019后,血液中總淋巴細胞、輔助細胞 (CD4) 和活化(CD25)T淋巴細胞和自然殺傷細胞的比例增加,說明該菌株可能是一種有效的益生菌膳食補充劑,有助于增強老年人細胞免疫。
提高抗病能力
Liao等人[18]研究了動物雙歧桿菌和絞股藍之間的相互作用,結果表明,通過益生元和益生菌之間的互惠作用,可以預防和抑制癌癥細胞的活動,首次揭示了動物雙歧桿菌具有預防和抑制癌癥的功能。研究者通過動物實驗表明,攝入動物雙歧桿菌活菌或死菌均可提高機體的抗體水平,提高巨噬細胞的吞噬活性,這對提高機體的抗感染能力、預防、抑制和殺死腫瘤細胞的產生具有重要作用[19, 20]。
應用情況
動物雙歧桿菌被廣泛應用于食品領域,常作為功能成分,被添加至發酵酸奶及其發酵飲料等多種產品中;是歐洲食品安全局(EFSA)資格認定(Qualified Presumption of Safety, QPS)名單收錄菌種、美國食品藥品監督管理局(FDA)公認安全物質(Generally recognized as safe, GRAS)名單收錄菌種。
動物雙歧桿菌常制成活菌制劑,如動物雙歧桿菌Bb-12滴劑,能夠調節和維護機體生態平衡。Pedret等[21]的研究,評估了口服動物雙歧桿菌乳亞種CECT 8145及其滅活菌株對人體肥胖的影響,結果表明,口服以上兩者都可以改善人體腹部肥胖,尤其是女性個體。
此外,動物雙歧桿菌在化妝品領域也表現出應用潛力,如在Huuskonen等[22]的研究中,通過口服動物雙歧桿菌乳亞種BI-04(1.75×109CFU)12周,對受試者的面部皮膚狀態進行評估,結果與對照組相比,第4周時眼角的總皺紋面積顯著減少。
國內外保藏情況
動物雙歧桿菌在國際各大保藏中心均有保藏,其中CICC保藏有模式菌株,與多家國際知名菌種保藏中心模式菌株等同編號,如:動物雙歧桿菌動物亞種CICC 6250等同編號ATCC 25527、JCM 1190 、DSM 20104;動物雙歧桿菌乳亞種CICC 24210等同編號CGMCC 1.2226、DSM 10140 、CIP 105265、JCM 10602,可用于分類學研究“種”的參考模型。
標準菌株CICC 6165,可作為陽性對照菌株,適用于《GB 4789.34-2016雙歧桿菌的鑒定》,同時可用于乳制品發酵,食品飲料、益生菌類保健食品生產。
此外,CICC還保藏有不同來源及用途的動物雙歧桿菌,如:動物雙歧桿菌CICC 21711、CICC 21715、CICC 21718等可用于酸奶及乳制品發酵;CICC 24930、CICC 24933等可用于科學研究。
特征特性
革蘭氏陽性菌,菌體呈短桿狀或棒桿狀(0.5-0.7×1.0-1.8 μm),長短不一,直或彎曲,單個或成對排列,常形成Y形或V形分支,無鞭毛,不產芽孢,不運動。


在雙歧桿菌瓊脂培養基(BBL)上36℃±1℃,厭氧培養48h,菌落為圓形、白色,凸起,表面光滑、濕潤、邊緣整齊。
專性厭氧,最適生長溫度37℃~41℃,最低生長溫度25℃~28℃,最高43℃~45℃;耐酸,起始生長pH值為6.7~7.0,在pH4.5~5.0以下或pH值為8.0~8.5以上的環境都不生長。
中國工業微生物菌種保藏管理中心(CICC)致力于提供高質量的微生物資源和專業化的技術服務,中心目前保藏有14000余株各類工業微生物菌種,526個屬,1477個種,其中乳酸菌1500余株,包含性能優良的動物雙歧桿菌,希望通過CICC對菌種的收集、保藏、質控和共享,使動物雙歧桿菌得到更廣泛的研究與應用,為我國工業領域的質量安全、技術創新和產業升級保駕護航。
參考文獻
[1] 王玉蓮, 田萬紅, 譚強來, 等. 雙歧桿菌的分類學研究與新進展[J]. 微生物學通報, 2015,42(01):185-191.
[2] Mitsuoka T. Vergleichende Untersuchungen über die Bifidobakterien aus dem Verdauungstrakt von Menschen und Tieren (1969)[J]. Zentralbl Bakteriol I Abt Orig, 1969,210:52-64.
[3] SCARDOVI V, TROVATELLI L D, ZANI G, et al. Deoxyribonucleic Acid Homology Relationships Among Species of the Genus Bifidobacteriurn [J]. International Journal of Systematic and Evolutionary Microbiology, 1971,21(4):276-294.
[4] SCARDOVI V, TROVATELLI L D. Bifidobacterium animalis (Mitsuoka) comb. nov. and the “minimum” and “subtile” Groups of New Bifidobacteria Found in Sewage[J]. International Journal of Systematic Bacteriology, 1974,24(1):21-28.
[5] Meile L, Ludwig W, Rueger U, et al. Bifidobacterium lactis sp. nov., a Moderately Oxygen Tolerant Species Isolated from Fermented Milk[J]. Systematic and Applied Microbiology, 1997,20(1):57-64.
[6] Cai Y, Matsumoto M, Benno Y. Bifidobacterium lactis Meile et al. 1997 is a subjective synonym of Bifidobacterium animalis (Mitsuoka 1969) Scardovi and Trovatelli 1974[J]. Microbiol Immunol, 2000,44(10):815-820.
[7] Ventura M, Zink R. Rapid identification, differentiation, and proposed new taxonomic classification of Bifidobacterium lactis[J]. Appl Environ Microbiol, 2002,68(12):6429-6434.
[8] Zhu L, Li W, Dong X. Species identification of genus Bifidobacterium based on partial HSP60 gene sequences and proposal of Bifidobacterium thermacidophilum subsp. porcinum subsp. nov.[J]. International Journal of Systematicand Evolutionary Microbiology, 2003,53:1619-1623.
[9] Masco L, Ventura M, Zink R, et al. Polyphasic taxonomic analysis of Bifidobacterium animalis and Bifidobacterium lactis reveals relatedness at the subspecies level:reclassification of Bifidobacterium animalis as Bifidobacterium animalis subsp. animalis subsp. nov. and Bifidobacteriuml lactis as Bifidobacterium animalis subsp. lactis subsp. nov.[J]. International Journal of Systematic and Evolutionary Microbiology, 2004(54):137-1143.
[10] Mattarelli, F C, M M, et al. Different electrophoretic patterns of cellular soluble proteins in Bifidobacterium animalis. Microbiologica[J]. 1992,15(1):71-74.
[11] 解讀關于《可用于食品的菌種名單》和《可用于嬰幼兒食品的菌種名單》更新的公告(2022年第4號)[Z].
[12] T M, K H. The fecal flora in man. I. Composition of the fecal flora of various age groups[J]. Zentralbl Bakteriol Orig A, 1973,223(2):333-342.
[13] Vernazza C L, Gibson G R, Rastall R A. Carbohydrate preference, acid tolerance and bile tolerance in five strains of Bifidobacterium[J]. Journal of Applied Microbiology, 2006,100(4):846-853.
[14] Matsumoto M, Ohishi H, Benno Y. H+-ATPase activity in Bifidobacterium with special reference to acid tolerance[J]. Int J Food Microbiol, 2004,1(93):109-113.
[15] 彭晨芮, 李金星, 王一媚, 等. 動物雙歧桿菌乳亞種BB-12與健康[J]. 營養學報, 2023,45(02):120-126.
[16] Martins A K S, Martins F S, Gomes D A, et al. Evaluation of in vitro antagonism and of in vivo immune modulation and protection against pathogenic experimental challenge of two probiotic strains of Bifidobacterium animalis var. lactis[J]. Archives of microbiology, 2010, 192: 995-1003.
[17] Gill H S, Rutherfurd K J, Cross M L, et al. Enhancement of immunity in the elderly by dietary supplementation with the probiotic Bifidobacterium lactis HN0191–3[J]. American Journal of Clinical Nutrition, 2001,74(6):833-839.
[18] Liao W, Khan I, Huang G, et al. Bifidobacterium animalis: the missing link for the cancer-preventive effect of Gynostemma pentaphyllum[J]. Gut Microbes, 2021,13(1):1847629.
[19] 范金波, 侯宇, 周素珍, 等. 雙歧桿菌增強小鼠機體的免疫功能[J]. 微生物學報, 2015,4(55):484-491.
[20] Chiang B L, Sheih Y H, Wang L H, et al. Enhancing immunity by dietary consumption of a probiotic lactic acid bacterium (Bifidobacterium lactis HN019): optimization and definition of cellular immune responses[J]. European Journal of Clinical Nutrition, 2000,54(11):849-855.
[21] Pedret, A, Valls, R M, Calderón-Pérez, L. et al. Effects of daily consumption of the probiotic Bifidobacterium animalis subsp. lactis CECT 8145 on anthropometric adiposity biomarkers in abdominally obese subjects: a randomized controlled trial. Int J Obes 43, 1863-1868 (2019).
[22] Huuskonen L, Lyra A, Lee E, Ryu J, Jeong H, Baek J, Seo Y, Shin M, Tiihonen K, Pesonen T, et al. Effects of Bifidobacterium animalis subsp. lactis Bl-04 on Skin Wrinkles and Dryness: A Randomized, Triple-Blinded, Placebo-Controlled Clinical Trial. Dermato. 2022; 2(2):30-52.


